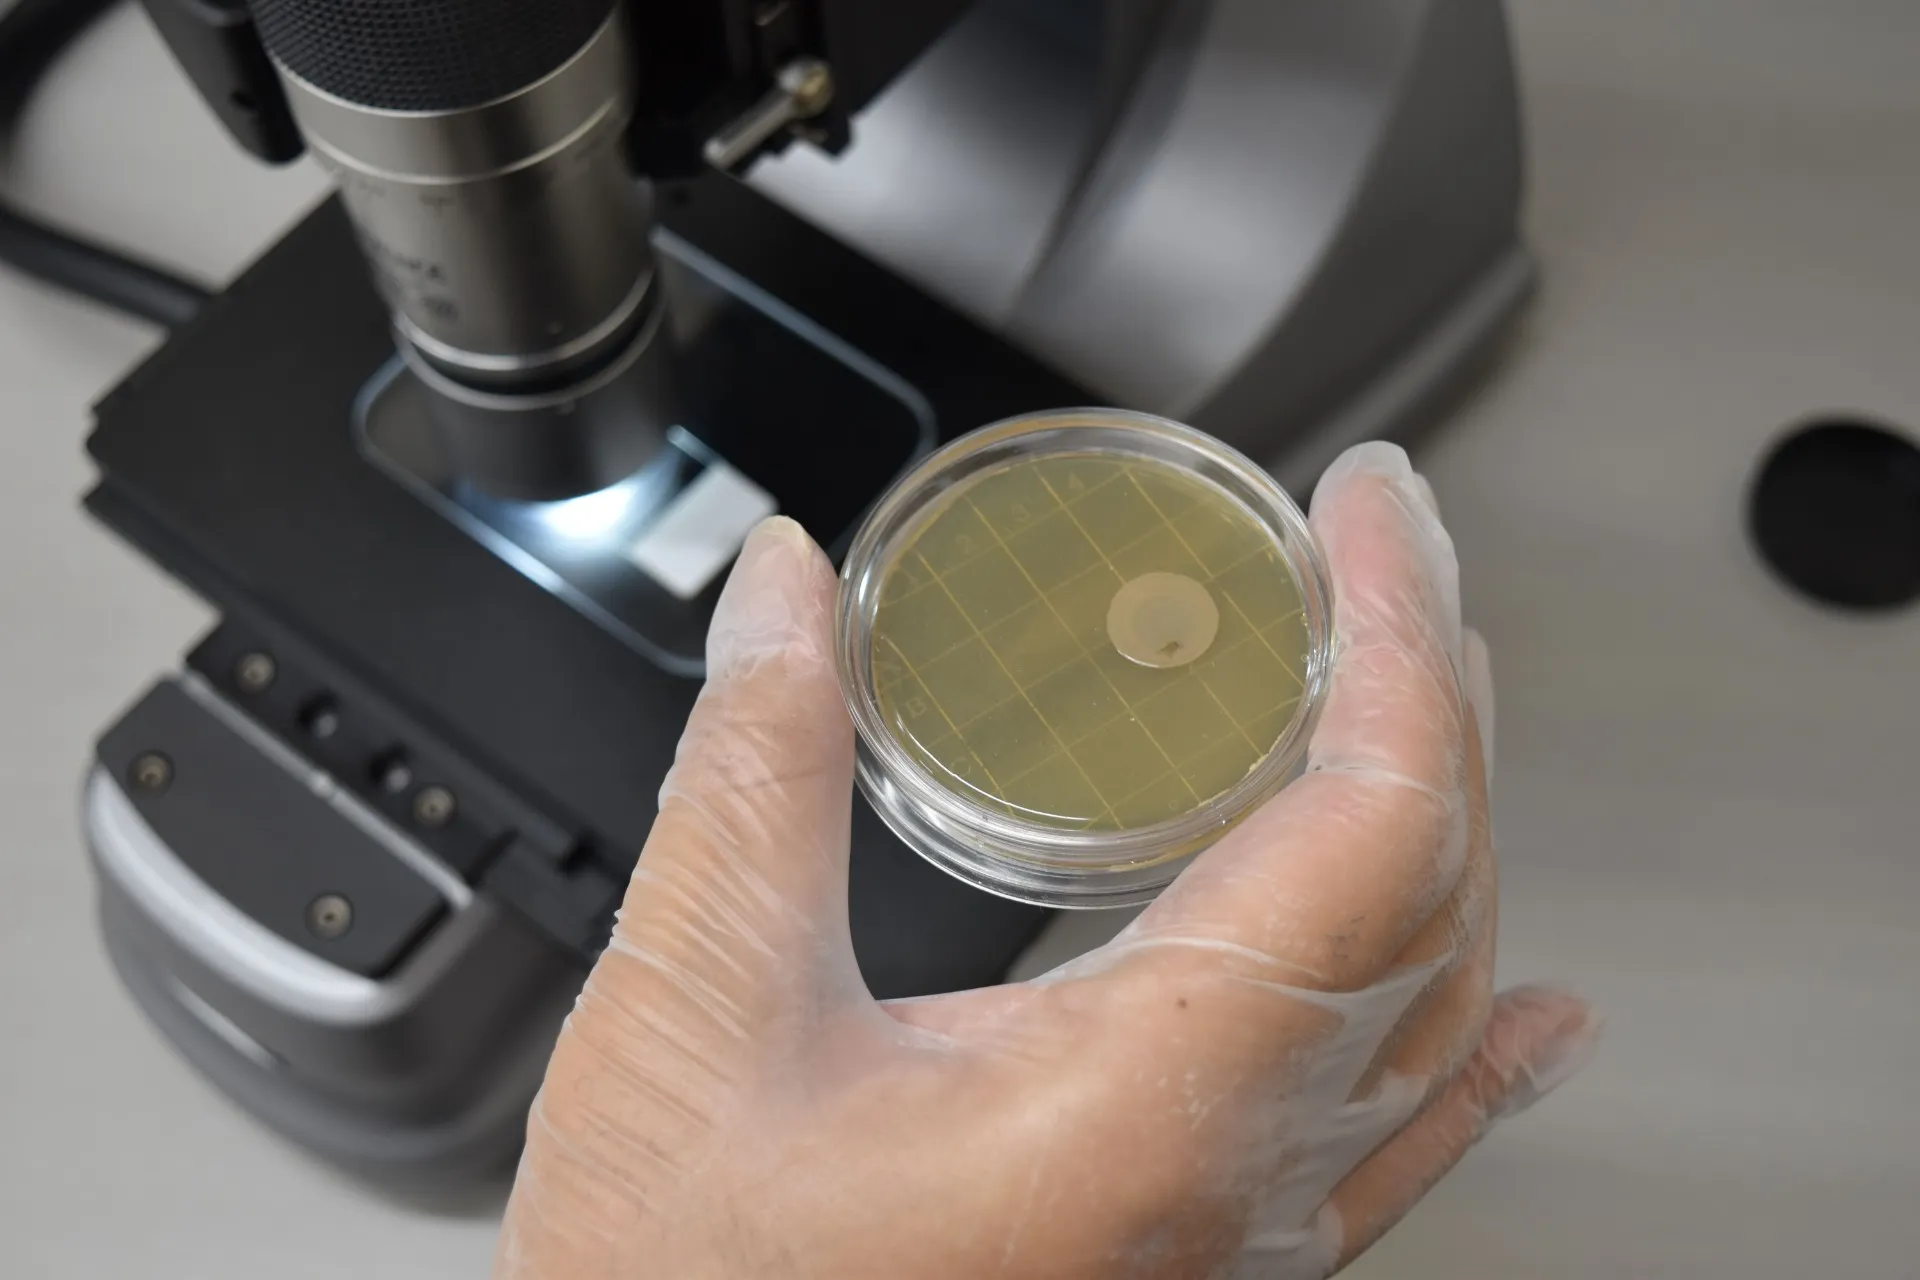

【木桶のシャンパンクーラーにカビ!?】ドンペリニヨン木桶クーラーの正しい保管とカビ対策ガイド|高級木製品を守る方法
2026/02/14
【木桶のシャンパンクーラーにカビ!?】
ドンペリニヨン木桶クーラーの正しい保管とカビ対策ガイド|高級木製品を守る方法
ドンペリニヨンの木桶クーラーがカビる原因とは?高級シャンパンクーラーを美しく保つための湿気対策と予防法をわかりやすく解説します!
こんにちは😊
MIST工法®カビバスターズ東海です。
最近、「木桶のシャンパンクーラーにカビが出てしまった…」「ドンペリニヨンの木桶クーラーに黒い斑点が…これってカビ?」というご相談が増えています🍾✨
特にドンペリニヨンの木桶クーラーは、記念日やパーティー、店舗ディスプレイなどで使われる特別なアイテム。見た目も重厚で高級感があり、「一生モノ」として大切にされている方も多いですよね。
ですが実は、木製品はとてもカビが発生しやすい素材なのです😢
氷や水を入れるシャンパンクーラーは特に湿気が多く、使用後にしっかり乾燥させないと内部に水分が残り、そこからカビが発生してしまいます。
「少しの黒ずみだから大丈夫」
「拭いたら消えたから問題ない」
そう思って放置してしまうと、内部までカビが広がっていることもあります⚠️
大切な木桶クーラーを長く美しく保つために、今回は
✔ なぜ木桶クーラーにカビが生えるのか
✔ 自分でできる予防方法
✔ やってはいけないNG対策
✔ 専門業者に相談すべきケース
を、どなたでもわかるようにやさしく解説していきます✨
手に負えない木桶クーラーのカビトラブルは、MIST工法®カビバスターズ東海にご相談ください😊
大切な高級木製品を守るお手伝いをいたします。
目次
木桶シャンパンクーラーはなぜカビやすいの?
木桶のシャンパンクーラーやドンペリニヨンの木桶クーラーは、特別な時間を演出する高級アイテムとして人気があります。しかし、その魅力的な見た目とは裏腹に、「カビが生えやすい」という悩みを抱えている方も多いのが現実です。本章では、なぜ木桶クーラーがカビやすいのか、その原因をわかりやすく丁寧に解説します😊
まず結論から言うと、木桶クーラーがカビやすい最大の理由は「湿気」と「素材の性質」です。
木桶は水に強い印象がありますが、実は木自体が水分を吸収しやすい性質を持っています。アイスバケットとして使用すると、氷や水分が長時間内部に残りやすく、この「湿った環境」がカビ発生の最大の原因になります。
一般的に高級シャンパンクーラーとして使われる木桶タイプは、氷をたくさん入れて使用することが多いため、常に内部が湿った状態になります。しかも氷が溶けるほど水分は増え、木材の繊維の間や継ぎ目にじわじわと浸透していきます。この水分が完全に乾かないまま保管されると、カビにとっては「理想的な繁殖環境」になってしまいます🍄
特に注意したいのが次のような箇所です:
木の継ぎ目や接合部分
底の隙間
金具や留め具の周囲
表面の目に見えない僅かな凹凸
これらの場所は、水分がたまりやすく、見た目では乾いているように見えても内部に水が潜んでいることがあります。木材は水を吸収することで膨張し、乾燥すると収縮します。この膨張・収縮の繰り返しが木材の内部に微細な隙間をつくり、そこに水分が入り込むと気づかぬうちにカビが発生してしまいます。
また、木材内部は空気の循環が悪いため、湿気がこもりやすいという性質もあります。見た目では異常がなくても、木の奥深くにカビが根を張っているケースもあり、放置すると黒ずみや変色、嫌な臭いの原因にもなります😢
さらに、使用後のケアが不十分だとさらにリスクが高まります。例えば、「外側は拭いたけれど内側はそのまま」「氷を捨てたら放置してしまった」というケースは非常に多く、このような状態が続くとカビはどんどん進行していきます。
カビが発生すると、見た目の美しさが損なわれるだけでなく、木桶クーラーの耐久性にも悪影響を与えます。木が湿った状態で長時間放置されると、木材自体が劣化してしまい、割れや反りの原因になることもあります。特に高級アイテムであるドンペリニヨンの木桶クーラーは、価値を落とさないためにもカビ対策は必須です✨
以上のように、木桶シャンパンクーラーがカビやすい原因は「湿気が溜まりやすく、乾燥しにくい素材特性」にあります。
木の性質を理解し、カビ予防につながる習慣を身につけることが、長く美しく使い続けるための第一歩です。
次章では、実際にカビになってしまった状態の見分け方や、初期段階でできるセルフケア方法についてわかりやすく解説していきますので、ぜひ最後までお読みください😊
※木桶クーラーのカビトラブルで困ったら、MIST工法®カビバスターズ東海にお気軽にご相談ください✨
素人でもわかりやすく丁寧にアドバイスいたします。
これってカビ?見分け方
木桶シャンパンクーラーのカビの見分け方
木桶のシャンパンクーラーやドンペリニヨンの木桶クーラーは、美しい木目と高級感が魅力ですが、その反面「カビが発生しているのかどうか判断しにくい」と悩む方も多いのではないでしょうか?
特に木製品は、経年変化による色の変化や水シミとカビの違いが分かりにくいため、正しい見分け方を知っておくことが大切です。ここでは、一般の方でもわかりやすいカビの見分け方について詳しく解説します😊
🔍①黒いポツポツはカビのサイン!
木桶クーラーの内側や継ぎ目、底部分などに「黒いポツポツ」が見られる場合、それはカビである可能性が高いです。
黒カビ(アスペルギルスやクラドスポリウムなど)は湿気の多い木材に発生しやすく、時間が経つと徐々に広がっていきます。初期のうちは小さくても、放置しておくと面積が広がり、木材の色が暗く変わることがあります。
🔎②白い粉のようなものは要注意!
白っぽい粉や膜のようなものが表面に発生している場合、これもカビの可能性があります。
木材の表面に発生する白カビは一見「塩の結晶」や「白く変色しただけ」と勘違いされがちですが、顕微鏡で見るとカビの菌糸が広がっているケースが多いです。
特に湿度が高い場所や保管状態が悪い場合は白カビが発生しやすいので、見つけたらすぐに対策が必要です。
👃③嫌なニオイがする場合もカビの可能性大
カビが発生している木桶クーラーは、独特の「カビ臭いニオイ」がすることがあります。
これはカビ菌が繁殖する際に発する揮発性物質によるものです。木桶は内部が湿りやすく、空気が循環しにくい構造のため、カビ臭がこもりやすくなります。
「少し湿ったにおいがする」と感じたら、それは早期のカビ発生のサインかもしれませんので注意が必要です。
🪵④色の変色や斑点に注意
木材は水分を吸うことで色が濃くなったり、シミのように見える箇所が出たりすることがありますが、シミとカビは見分けが必要です。
以下のポイントが「カビの可能性」を高めます👇
色が濃くなっている部分が不自然
ムラ状の斑点が複数ある
周囲より明らかに色味が違う
色の変化だけではなく、表面がざらついていたり、触ると粉のようなものが付く場合はカビの可能性が高いので、早めにチェックしましょう😊
🧪⑤拭き掃除で取れない場合は要注意
軽い汚れや色の変化であれば、柔らかい布で拭けば落ちることもありますが、カビは表面だけでなく木の内部に根を張る性質があります。
そのため、以下のような場合はカビが深く進行している可能性が高いです:
✔ 拭いても黒い点が消えない
✔ 拭くと逆に広がってしまう
✔ 触ると粉っぽい
これらはカビの菌糸が木材内部に入り込んでいるサインです。こうした場合は専門的な処理を検討した方が安心です。
📌まとめ:こんな症状はカビの可能性が高い!
木桶シャンパンクーラーに以下の症状がある場合は、カビの可能性が高いと考えられます👇
🌟 黒いポツポツがある
🌟 白い粉のようなものが付いている
🌟 カビ臭がする
🌟 ムラ状の色変化がある
🌟 拭いても取れない
木製品は見た目だけで判断しにくいことが多いため、少しでも「カビかも?」と感じたら早めのケアが重要です。
カビの放置は広がりやすく、木桶クーラーの価値も下げてしまいます😥
🏢困ったらMIST工法®カビバスターズ東海へ!
木桶シャンパンクーラーやドンペリニヨンの木桶クーラーのカビトラブルは、MIST工法®カビバスターズ東海にお任せください😊
どんな小さな変化でも丁寧にチェックし、あなたの大切な木製アイテムを守るお手伝いをいたします✨
お気軽にご相談くださいね🍀
自分でできる木桶シャンパンクーラーのカビ予防法
木桶のシャンパンクーラーやドンペリニヨン木桶クーラーは、一度カビが発生してしまうと見た目も使い心地も台無しになってしまうことがあります。しかし、実は日頃のちょっとしたケアでカビの発生を大幅に防ぐことができます。ここでは、誰でも簡単にできる木桶クーラーのカビ予防法をわかりやすく丁寧に解説します😊
✔ 使用後は必ず氷と水を捨てる
シャンパンクーラーは氷と水を入れて使うため、使用後にそのまま放置してしまうと内部に水分が残りやすくなります。
水分が残ったままだと、木材の内部が湿気た状態になってしまい、そこからカビが発生する可能性が高まります。
そのため、使用後は必ず氷と水をすぐに捨てることが基本です。
その後は柔らかい布やキッチンペーパーで、内部の水分をできるだけ吸い取るようにしましょう。こうした簡単なステップを習慣にするだけで、カビのリスクはぐんと減ります。
✔ 柔らかい布で水分を拭き取る
木桶クーラーの内部は表面だけでなく、継ぎ目や隙間にも水分が入り込みやすいです。そのため、ただ表面を拭くだけでは不十分なことがあります。
柔らかい布やマイクロファイバークロスを使用して、丁寧に隅々まで水分を拭き取りましょう。
⚠️ このとき、ゴシゴシ強くこするのは避けてください。木の表面が傷つくとそこに水分が留まりやすくなり、逆にカビが発生しやすくなってしまいます。
✔ 風通しの良い場所で完全に乾燥させる
水分を拭き取った後、最も大切なのは「完全に乾燥させること」です。
見た目では乾いているように見えても、木材の内部にはまだ水分が残っていることがあります。湿気が残ったまま保管すると、カビが再び発生してしまうリスクが高まります。
そこでおすすめなのが、風通しの良い場所で乾燥させる方法です。具体的には以下のような場所が適しています👇
✨ 室内でも窓際の風通しの良いスペース
✨ 扇風機やサーキュレーターで空気を循環させる
✨ 直射日光の当たらない屋外の風通しの良い場所
このように空気の流れを作ることで、木桶クーラーが内部までしっかり乾き、カビの発生を防ぐことができます。
✔ 収納時は除湿剤やシリカゲルを活用
乾燥させた後、保管する際にもカビ予防は続きます。湿度が高い季節や湿気が多い場所に保管する場合は、除湿剤やシリカゲルを木桶クーラーの内部や収納スペースに入れておくと効果的です。
特に湿度が60%以上になるとカビが発生しやすくなると言われていますので(※一般的なカビ発生条件参考)、除湿剤は湿度コントロールに非常に有効です。
✔ 定期的にチェックして早めの対策を
カビの発生を完全に防ぐことは難しいケースもありますので、定期的なチェックもカビ予防には重要です。
最低でも月に1〜2回程度は木桶クーラーの内部をチェックしてみましょう👇
・黒い点や白い粉のようなものがないか
・嫌なカビ臭がしていないか
・木材の色がムラになっていないか
こうした簡単なチェックだけでも、カビの初期兆候を見つけることができます。早期発見は早期対策につながり、結果として大切な木桶クーラーを守ることになります。
📌まとめ
木桶のシャンパンクーラーやドンペリニヨン木桶クーラーのカビ予防は、以下のステップで大きく改善できます👇
✔ 使用後は氷と水を必ず捨てる
✔ 柔らかい布で丁寧に水分を拭き取る
✔ 風通しの良い場所で完全に乾燥させる
✔ 収納時は除湿剤やシリカゲルを活用
✔ 定期的なチェックを行う
これらは特別な技術や道具がなくてもできる基本的なケア方法です😊
日頃のちょっとした習慣が、高級木製アイテムの美しさを長持ちさせ、カビトラブルを未然に防ぐ力になります。
🏢困ったらMIST工法®カビバスターズ東海へ!
木桶シャンパンクーラーのカビ予防に不安がある方や、「これってカビ?」と気になる方は、ぜひMIST工法®カビバスターズ東海にお気軽にご相談ください✨
専門スタッフが丁寧にアドバイスいたします😊
やってはいけない木桶シャンパンクーラーのカビ対策
木桶のシャンパンクーラーやドンペリニヨン木桶クーラーは、美しく高級感のあるアイテムとして多くの方にご愛用いただいています。しかし、カビの発生に対して間違った対策をしてしまうと、逆に木材を傷めてしまう・カビを広げてしまうことがあります😢
ここでは、木製シャンパンクーラーのカビ対策として「やってはいけないNG行為」を、わかりやすく丁寧に解説します。
❌NG①:塩素系漂白剤を大量に使う
「カビが発生したら漂白剤で消せばいい」と考える方も多いですが、塩素系漂白剤は木材にとって非常に強力すぎる薬剤です。
木材の細い繊維の中まで漂白剤が入り込むと、次のような問題が起きる可能性があります👇
木材の色が変わってしまう
表面が硬化して割れやすくなる
木目の美しさが失われる
さらに、漂白剤自体が木材に残留し、後から変色や変質を引き起こすこともあります。
カビが落ちたように見えても、木桶クーラー本来の風合いが損なわれてしまうリスクが高いため、塩素系漂白剤の使用はおすすめできません。
❌NG②:ゴシゴシ強く削る・研磨する
カビの黒い点やシミが見えると、「強くこすれば取れる」と考えてしまう方もいますが、これはとても危険です⚠️
木材は柔らかい素材です。強くこする・削る行為を繰り返すと次のような弊害が出ます👇
表面の保護層が削れてしまう
木目が荒れて水分が入りやすくなる
触り心地が粗くなりカビ再発の原因に
特にサンドペーパーや金属ブラシのような研磨道具を使っての強い摩擦は、木桶クーラーの寿命を縮めるだけでなく、見た目を大きく損なう可能性があります。
❌NG③:濡れたまま保管する
カビの原因の多くは「湿気」です。
しかし、使用後に濡れたまま保管してしまう方は非常に多く、「気づいたらカビが生えていた」というパターンの代表例です。
濡れたままの状態で保管すると、木材の内部に水分が浸透し、乾燥しにくくなります。その結果、以下のような悪循環が生まれます👇
✔ 木材内の湿度が高い状態が続く
✔ カビ菌が繁殖しやすい環境に
✔ カビが内部深くまで成長してしまう
✔ カビ臭が発生する
使用後は必ず水分を拭き取り、風通しの良い場所で完全に乾燥させてから保管することが基本です。
❌NG④:熱湯や強い薬剤で消毒する
「熱湯をかければカビは死ぬ」
「強い消毒薬を使えば安心」と思う方もいますが、木材は熱や強い薬剤に弱いため、以下のような問題を引き起こす可能性あります👇
木が反ってしまう
乾燥時に割れが発生する
木の内部がさらにダメージを受ける
熱や薬剤が木の内部に作用すると、カビを一時的に見えなくすることはできても、木材自体が傷んでしまい長期的には悪影響になります。
❌NG⑤:見えない部分のカビを放置する
表面上だけカビを取り除いて安心してしまう方もいますが、木材は内部にまで湿気が入り込みやすく、カビの根が奥深くまで伸びていることが少なくありません。
見た目には取れても、内部に残ったカビは再び表面へと出てくることがあります。
このようなケースは特に注意が必要で、素人判断では見つけにくいため、定期的に内部までチェックすることが重要です。
📌まとめ:木桶シャンパンクーラーのNGカビ対策
以下は木製シャンパンクーラーのカビ対策として絶対に避けたい行為です👇
❌ 塩素系漂白剤を大量に使う
❌ 強く削る・研磨する
❌ 濡れたまま保管する
❌ 熱湯や強力薬剤で消毒する
❌ 見えない部分のカビを放置する
これらは一見カビを落とすように見えても、木桶クーラーの価値を下げ、かえってカビを悪化させる原因になることがあります。
🏢困ったらMIST工法®カビバスターズ東海へ!
木桶シャンパンクーラーやドンペリニヨン木桶クーラーのカビ対策でお困りの場合は、ぜひMIST工法®カビバスターズ東海にご相談ください😊
カビを正しく判断し、木製アイテムを守るための安全な対策方法をご提案します✨
カビ専門業者に相談すべき木桶シャンパンクーラーのカビトラブル
木桶のシャンパンクーラーやドンペリニヨン木桶クーラーは、見た目の美しさと使い心地の良さから特別なシーンで活躍する高級アイテムです。しかし、**「これはもう自分では手に負えない…」**と感じるカビトラブルは意外と多く、放置するとカビが広がったり木材の劣化が進んでしまったりすることがあります。
そこで本章では、どのような状態になったら「専門業者に相談すべきか」を丁寧にわかりやすく解説します😊
🔎①何度もカビが再発する
木桶シャンパンクーラーにカビが一度発生して、家庭のケアで表面はきれいになったように見えても、何度も同じ場所にカビが出ることがあります。
これには次のような理由が考えられます👇
✔ カビの原因が根本的に解消されていない
✔ 木材内部にカビの菌糸が残っている
✔ 湿気環境が改善されていない
自己流で対策をしても、カビが再発してしまう場合は、根本原因の特定と確実な処理が必要です。
こうしたケースでは、専門知識と適切な技術を持った業者に相談することが早期解決につながります。
🪵②木材内部まで黒ずんでいる
表面に見えるカビは比較的対応しやすいケースですが、木材内部深くまで黒ずみが進行している場合は要注意です。
木は水分を吸収しやすいため、カビが内部にまで浸透してしまうと、目で見ただけでは進行度がわかりにくいことがあります。
このような深いカビは表面の拭き掃除では解消できないことが多く、専門的な処理が必要となるケースが多いです。
放置してしまうと木材の劣化が進み、最悪の場合は木の割れや反りにつながる可能性もあります😥
👃③カビ臭が取れない
木桶シャンパンクーラーにカビが発生すると、「カビ臭」が気になる方も多いと思います。
カビ臭は、カビ菌が繁殖した際に発する揮発性有機化合物(VOCs)によるものですが、臭いが取れない場合は内部までカビ菌が広がっている可能性があります。
表面の汚れを落としても臭いが残る場合、次のような原因が考えられます👇
✔ 木材の内部にカビ菌が残存
✔ 湿気がこもりやすい環境で保管している
✔ 表面だけの掃除で済ませてしまった
このような場合も、専門業者による診断と処理が必要になることが多いです。
🛠④高級木製品だからこそ失敗したくない
ドンペリニヨンの木桶クーラーは高級品であり、価値も価格も非常に高いアイテムです。そのため、素人の自己流のカビ対策で失敗したくない方も多いはずです。
間違った対策は木材を損なうだけでなく、見た目や風合いを損なってしまうリスクがあります。
そんな時は迷わず専門家にご相談ください。
木材の特性・カビの進行度・保管環境を総合的に判断し、安心・安全な対策方法を提案してくれます。
📌⑤木桶クーラーの価値を守るための判断基準
以下のような症状が当てはまる場合は、専門業者に相談することをおすすめします👇
✔ カビが何度も再発する
✔ 木材内部まで黒ずんでいる
✔ カビ臭が取れない
✔ 木材の変色や劣化が目立つ
✔ 自分で対処する自信がない
これらは「誰でも簡単に解決できるレベル」を超えたサインです。
特に高級木製品は、一度の失敗で取り返しのつかない状態になることもあるため、早めの相談が重要です✨
🏢MIST工法®カビバスターズ東海へご相談ください!
木桶シャンパンクーラーやドンペリニヨン木桶クーラーのカビトラブルは、ぜひMIST工法®カビバスターズ東海にお任せください😊
✔ 初めてで不安な方
✔ 自分で対策しても改善しない方
✔ 大切な木製アイテムを守りたい方
専門スタッフが丁寧に診断し、最適なアドバイス・サポートをご提供します✨
カビトラブルでお悩みの際は、ぜひお気軽にご相談ください😊
まとめ|木桶のシャンパンクーラー・ドンペリニヨン木桶クーラーのカビ対策は早めの判断が大切です
木桶のシャンパンクーラーやドンペリニヨンの木桶クーラーは、特別な時間を演出する高級アイテムです。重厚感のある木目、美しいフォルム、そしてラグジュアリーな雰囲気は、パーティーや店舗ディスプレイ、ご自宅での記念日など、さまざまなシーンで活躍します🍾✨
しかしその一方で、木製という素材の特性上、「湿気に弱い」「水分を吸収しやすい」「乾燥に時間がかかる」という特徴があり、カビが発生しやすい環境が整いやすいというリスクも抱えています。
今回のブログでは、
✔ 木桶シャンパンクーラーがカビやすい理由
✔ カビの見分け方
✔ 自分でできる予防方法
✔ やってはいけないNG対策
✔ 専門業者に相談すべきケース
について、できるだけわかりやすく解説してきました。
特に重要なのは、「カビは見えない部分で進行していることがある」という点です。黒いポツポツや白い粉状のもの、取れないカビ臭がある場合は、木材内部までカビが入り込んでいる可能性があります。表面だけを拭き取って安心してしまうと、しばらくして再発するケースも少なくありません。
また、塩素系漂白剤や強い薬剤を使う、ゴシゴシ削るといった自己流の対策は、木桶クーラー本来の風合いや価値を損なう原因になります。ドンペリニヨンの木桶クーラーのような高級アイテムは、特に慎重な対応が必要です。
木桶シャンパンクーラーのカビ対策で最も大切なのは、
🌿 使用後の徹底した乾燥
🌿 湿度管理
🌿 定期的なチェック
🌿 異変を感じたら早めに相談
という「早期対応」です。
「これってカビかな?」
「黒ずみが気になるけど判断がつかない」
「何度も再発してしまう」
そのようなお悩みがある場合は、無理をせず専門家にご相談ください。
MIST工法®カビバスターズ東海は、木桶シャンパンクーラーやドンペリニヨン木桶クーラーのカビトラブルに対応しております。大切な高級木製品の価値を守るため、状況に応じた適切なアドバイスとサポートをご提供いたします。
木桶クーラーのカビは放置すると広がりますが、早めの対応で十分に守ることが可能です😊
あなたの大切な木製アイテムを、これからも長く美しく使い続けるために。
木桶のシャンパンクーラー・ドンペリニヨン木桶クーラーのカビ問題でお困りの際は、ぜひMIST工法®カビバスターズ東海へお気軽にご相談ください。
安心して使える状態を取り戻すお手伝いをさせていただきます🍀✨
よくある質問Q&A
Q1. 木桶のシャンパンクーラーに黒い点があります。これはカビですか?
黒いポツポツや斑点がある場合、カビである可能性が高いです。特に氷を使用した後に乾燥が不十分だった場合、木材の内部に水分が残り、黒カビが発生しやすくなります。
ただし、水シミや経年変化による変色との見分けは難しいこともあります。拭いても取れない、広がっている、カビ臭がある場合はカビの可能性が高いため、早めの確認をおすすめします。
Q2. ドンペリニヨンの木桶クーラーはなぜカビやすいのですか?
ドンペリニヨンの木桶クーラーは木製のため、水分を吸収しやすいという特性があります。シャンパンを冷やすために氷を使用することで、内部が長時間湿った状態になります。
木は一度水分を吸うと内部まで浸透しやすく、完全乾燥しないとカビが繁殖しやすい環境になります。特に継ぎ目や底部分は水分が溜まりやすいため注意が必要です。
Q3. 木桶クーラーのカビは自分で取れますか?
軽度で表面のみの場合は、適切な乾燥と優しい清掃で改善することもあります。しかし、木材内部にまでカビが入り込んでいる場合は再発しやすくなります。
塩素系漂白剤や強い薬剤の使用は、木材を傷める原因になるため注意が必要です。高級木製品の場合は、無理な自己処理を避け、専門家に相談することが安心です。
Q4. 木製シャンパンクーラーのカビ臭が取れません。どうすればいいですか?
カビ臭が残る場合、木材内部にカビ菌が残存している可能性があります。表面を拭くだけでは完全に除去できないことがあります。
何度も臭いが戻る場合や、乾燥させても改善しない場合は、専門的な診断を受けることをおすすめします。
Q5. 木桶シャンパンクーラーの正しい保管方法は?
使用後は必ず氷と水を捨て、柔らかい布で水分を拭き取り、風通しの良い場所で完全乾燥させることが重要です。
収納時は湿度が高くならないように除湿剤を活用すると効果的です。湿度60%以上になるとカビが発生しやすいため、湿度管理も大切です。
Q6. 木桶クーラーのカビは放置するとどうなりますか?
放置するとカビが広がり、木材内部まで浸透する可能性があります。見た目の問題だけでなく、木の劣化や割れ、反りにつながることもあります。
高級なドンペリニヨン木桶クーラーの場合、資産価値にも影響するため、早めの対応が重要です。
Q7. どのタイミングで専門業者に相談すべきですか?
以下のような症状がある場合は、専門業者への相談をおすすめします。
✔ 何度もカビが再発する
✔ 黒ずみが広がっている
✔ カビ臭が取れない
✔ 木材内部まで変色している
✔ 高級品なので失敗したくない
これらは自己対処の範囲を超えている可能性があります。
🏢木桶シャンパンクーラーのカビトラブルはMIST工法®カビバスターズ東海へ
木桶のシャンパンクーラーやドンペリニヨン木桶クーラーのカビ問題でお困りの方は、MIST工法®カビバスターズ東海へご相談ください。
「木桶 シャンパンクーラー カビ対策」
「ドンペリニヨン 木桶クーラー 黒カビ」
「木製 アイスバケット カビ 取り方」
このような検索でお調べの方にも、安心してご相談いただける体制を整えております。
大切な高級木製品を守るために、早めの判断と適切な対策が重要です。
お気軽にお問い合わせください。
Mold on Wooden Champagne Coolers – How to Protect Your Dom Pérignon Wooden Ice Bucket
Wooden champagne coolers, especially luxury pieces such as the Dom Pérignon wooden cooler, are elegant and prestigious accessories used in fine dining, hospitality, and private celebrations. However, due to the natural properties of wood and constant exposure to ice and moisture, mold growth can easily occur if proper drying and storage are not maintained.
Wood absorbs water quickly, and even after visible drying, internal moisture may remain trapped inside the fibers. This creates an ideal environment for mold spores to develop, especially in humid climates or poorly ventilated storage areas. Common signs include black spots, white powdery patches, discoloration, and persistent musty odor.
Improper cleaning methods such as chlorine bleach, harsh chemicals, aggressive scrubbing, or storing the cooler while damp can permanently damage the wood surface and increase future mold risks.
Preventive care includes:
• Immediate drying after use
• Proper air circulation
• Controlled humidity below 60%
• Regular inspection of joints and bottom areas
If mold keeps returning, penetrates deep into the wood, or produces strong odor, professional assessment is recommended.
For severe mold issues on wooden champagne coolers or luxury wine accessories, MIST Method® Mold Busters Tokai provides expert consultation and support to protect valuable wooden items.
Moisissure sur un seau à champagne en bois – Comment protéger votre seau Dom Pérignon
Les seaux à champagne en bois, notamment les modèles de luxe comme le seau Dom Pérignon en bois, sont des accessoires élégants utilisés dans les restaurants haut de gamme, les hôtels et les événements privés. Cependant, le bois est un matériau naturel qui absorbe facilement l’humidité, ce qui favorise le développement de moisissures.
Après utilisation avec de la glace, l’humidité peut pénétrer profondément dans les fibres du bois. Même si la surface semble sèche, l’intérieur peut rester humide, créant un environnement idéal pour la prolifération des spores de moisissure, surtout dans un environnement humide ou mal ventilé.
Les signes fréquents incluent :
• Taches noires
• Poudre blanche
• Odeur persistante
• Décoloration irrégulière
L’utilisation de produits chimiques agressifs ou d’eau de javel peut endommager le bois et aggraver le problème à long terme.
Pour prévenir la moisissure :
• Sécher immédiatement après usage
• Assurer une bonne ventilation
• Maintenir un taux d’humidité inférieur à 60 %
• Inspecter régulièrement les zones sensibles
En cas de récidive ou d’odeur persistante, une évaluation professionnelle est recommandée.
MIST Method® Mold Busters Tokai propose des conseils spécialisés pour protéger vos accessoires de luxe en bois contre la moisissure.
🍾木桶シャンパンクーラーのカビでお困りの方へ
「これってカビ?黒いポツポツが気になる…」
「ドンペリニヨンの木桶クーラーを傷めたくない」
「自己流で対処して失敗したくない」
そのようなお悩みがありましたら、
MIST工法®カビバスターズ東海へお気軽にご相談ください。
木製のシャンパンクーラーは非常にデリケートな素材です。
間違った処理をすると、風合いや価値を損なってしまう可能性があります。
まずはお気軽に、
📩 ホームページお問い合わせフォーム
📱 LINE無料相談
より、現在の状態のお写真をお送りください。
✔ 黒いポツポツがある
✔ カビ臭がする
✔ 何度も再発している
✔ 高級品なので慎重に対応したい
どんな小さなお悩みでも構いません。
専門スタッフが丁寧に確認し、最適なアドバイスをさせていただきます。
大切な木桶クーラーを守るために、
早めのご相談が安心につながります。
👉 ホームページお問い合わせフォームはこちら
👉 LINEで写真を送って無料相談する
お気軽にご連絡ください🍀✨
🍾 Concerned About Mold on Your Wooden Champagne Cooler?
Are you noticing small black spots on your wooden champagne cooler?
Do you want to protect your Dom Pérignon wooden bucket without damaging it?
Are you unsure whether it is mold or simple discoloration?
If so, please contact MIST Method® Mold Busters Tokai for professional consultation.
Wooden champagne coolers are delicate luxury items.
Improper cleaning methods may permanently damage the wood surface and reduce its value.
You can contact us easily through:
📩 Website Contact Form
📱 LINE Free Consultation (Send us photos)
Please send:
• Photos of the affected area
• Description of odor (if any)
• When the issue started
Our specialists will carefully review your situation and provide professional advice.
Early consultation helps prevent further mold spread and protects your valuable wooden accessories.
👉 Contact us via Website Form
👉 Send photos via LINE for Free Consultation
We are here to help you protect your luxury wooden items.
🍾 Problème de moisissure sur votre seau à champagne en bois ?
Vous remarquez de petits points noirs sur votre seau à champagne en bois ?
Vous souhaitez protéger votre seau Dom Pérignon sans risquer de l’endommager ?
Vous hésitez entre moisissure et simple décoloration ?
Contactez MIST Method® Mold Busters Tokai pour une consultation professionnelle.
Les seaux à champagne en bois sont des objets de luxe délicats.
Un nettoyage inadapté peut abîmer le bois et réduire sa valeur.
Vous pouvez nous contacter facilement via :
📩 Formulaire de contact sur notre site
📱 Consultation gratuite via LINE (envoyez des photos)
Merci de nous transmettre :
• Photos des zones concernées
• Présence éventuelle d’odeur
• Date d’apparition du problème
Nos spécialistes analyseront votre situation et vous fourniront des conseils adaptés.
Une intervention précoce permet de protéger vos accessoires de luxe en bois et d’éviter l’aggravation de la moisissure.
👉 Contactez-nous via le formulaire
👉 Envoyez vos photos via LINE
----------------------------------------------------------------------
カビバスターズ東海 (名古屋本社・東京支店)
本社:名古屋市中川区本前田町44
東京支店: 東京都品川区西五反田7丁目1−3 伸和五反田ビル 1階
フリーダイヤル 0120-147-215
----------------------------------------------------------------------